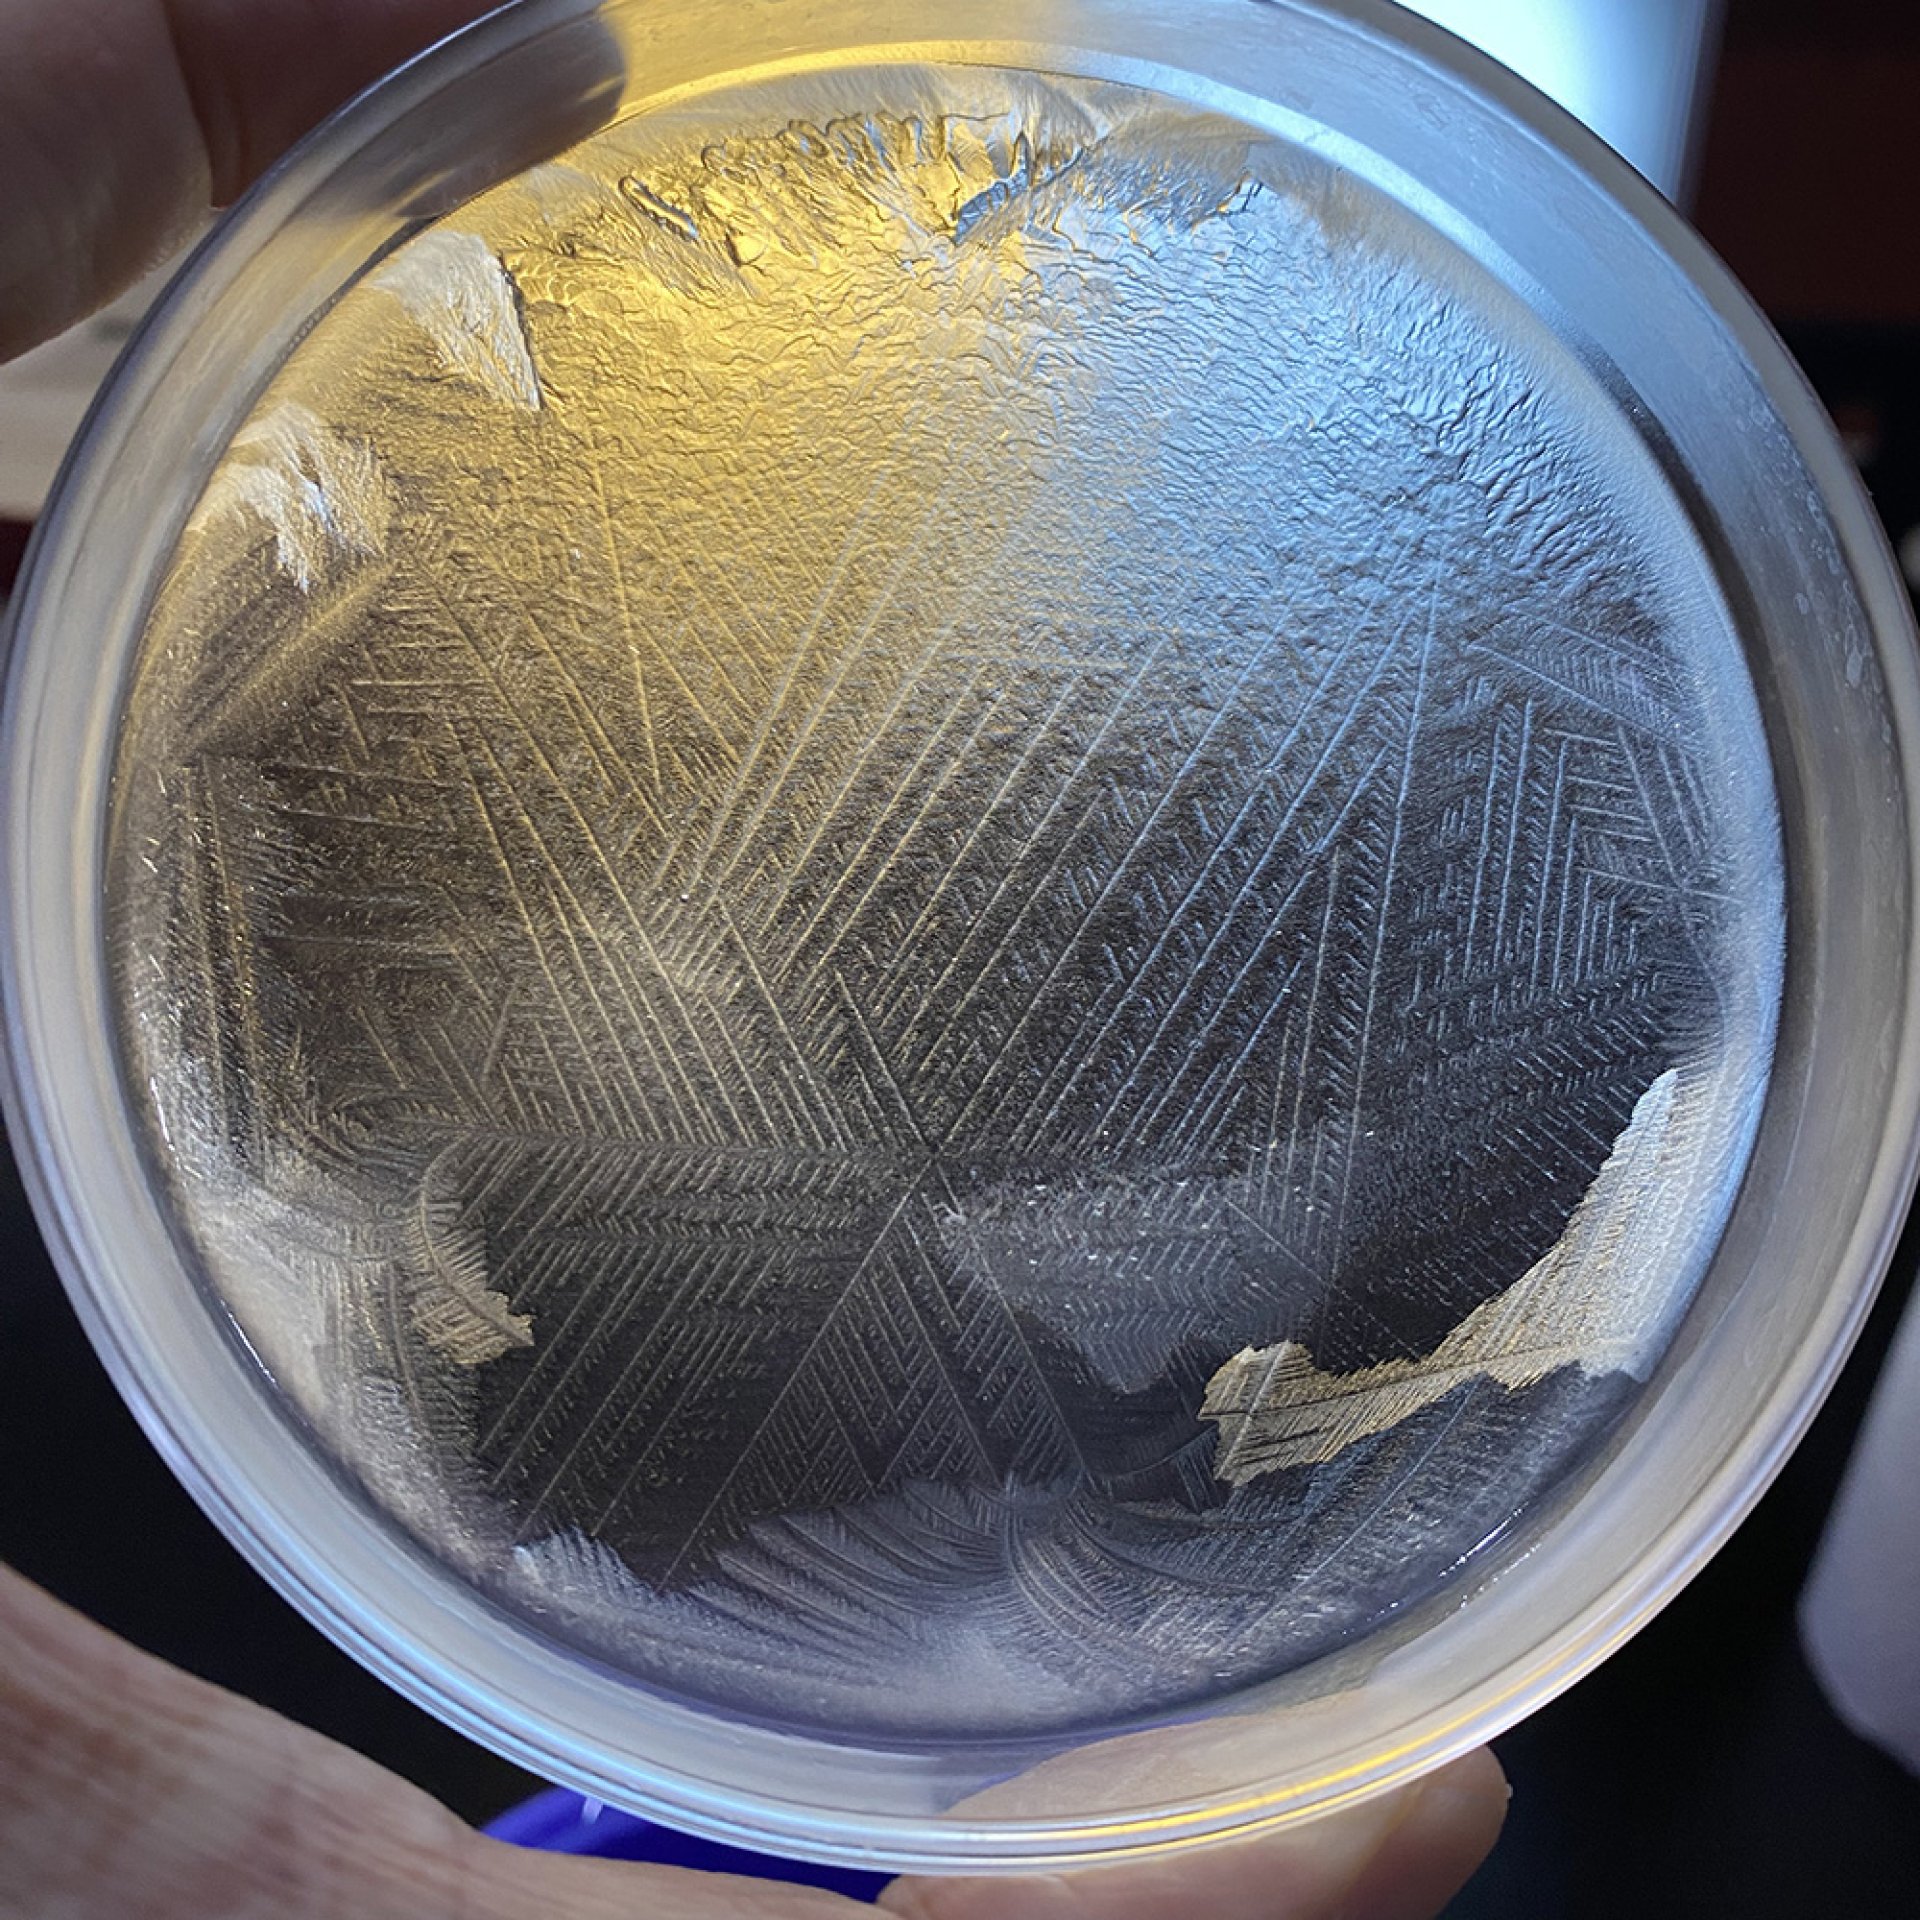

#6 ลวดลายที่สวยงามเมื่อน้ำพลังแม่เหล็ก RYAN WATER สัมผัสกับคำว่า "Love & Gratitude"
อัพเดทล่าสุด: 27 ก.ค. 2025
351 ผู้เข้าชม
วันนี้ผมเอาน้ำพลังแม่เหล็ก RYAN WATER ให้สัมผัสกับคำว่า Love & Gratitude และเอาไปแช่แข็งโดยวิธีเฉพาะทาง
ข้อมูล Aquaglyphs ที่ปรากฏขึ้นหลังจากแช่แข็งเป็นลวดลายรูปทรงหกเหลี่ยมที่ชัดเจนและสวยงามครับ


